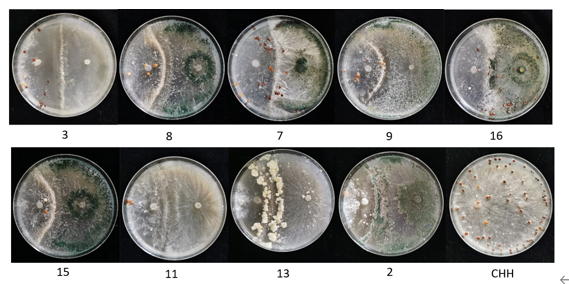
图片9.png 图片9.png

我院中药材根部病害生物防控取得突破进展
白绢病、根腐病等土传病害是危害中药材的重要病害,防治困难,严重时直接绝产,是中药材产量和品质提升,产业发展的最大障碍。江油附子产业受白绢病危害严重,很多化学药剂对其防效甚微,药农苦不堪言。
国家中药材产业技术体系绵阳试验站历时3年,终于在防治附子根部病害上取得重大突破。课题组成员叶坤浩前期通过对低毒、安全的化学药剂进行筛选,初步制定了适用于江油附子病害防控的技术规范,并于2022年7月发布。

图1 江油附子病害防控技术组装
为了进一步符合中药材生态栽培理念,课题组又从土壤微生物资源切入,从发病田块健康附子的根际微生物中筛选到一批高效优质的生防菌株,经过反复试验论证,筛选的菌株稳定性高、安全性好。接下来将对菌株进行规模化培育试验,该生防菌株的研发,有望填补白绢病的防治药剂空白,并且对环境无污染,符合中药材安全、有序、有效的生态发展理念。
图2 生防菌株对白绢病菌的拮抗效果
(中药材研究所 叶坤浩 供稿)